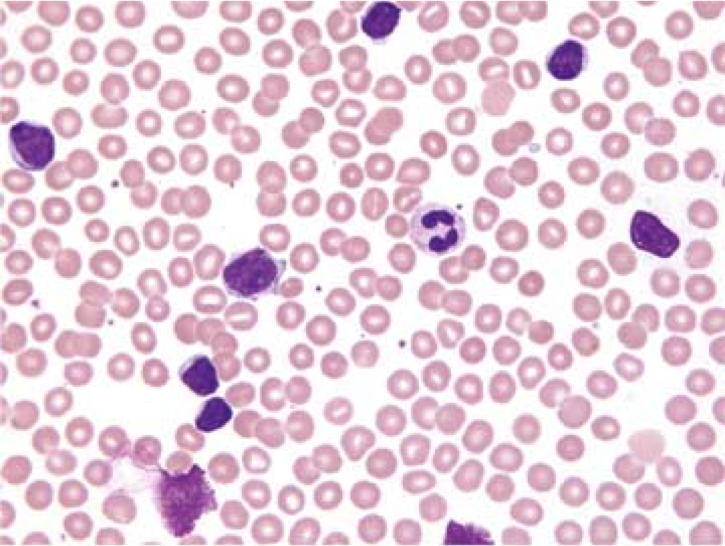

Immunophenotype of B-cell precursors in bone marrow
Immunophenotype of naive B-cells in lymphoid tissues
Immunophenotype of B-cells in follicular area (centroblasts and centrocytes)
Immunophenotype of plasma cell
Location of Ig promoters
IgH (14q32)
Ig lambda (22q11)
Ig kappa (2p12)
–> oncogene translocation to these areas causes overexpression of oncogene product
Cells thought to cause CLL
Memory B-cells found in the marginal zone of the lymph node
Clinical presentation of chronic lymphocytic leukemia/lymphoma
Lymphocytosis in older males –> high familial incidence
Unexplained recurring infection due to hypogammaglobulinemia (infection is the most common cause of death)
Sites involved in CLL/SLL
Peripheral blood > bone marrow, lymph nodes
Peripheral blood morphology of CLL/SLL
Small lymphocytes, little cytoplasm and mature dense chromatin –> monomorphic appearance
Smudge cells
Lymph node morphology of CLL/SLL
“Pseudofollicular” –> collections of slightly larger cells undergoing DNA synthesis

Cytogenetics of CLL/SLL
Ranked by prognosis
del13 > trisomy 12 > del11, del17 (p53 region… bad)
Immunophenotype of CLL/SLL
Clinical presentation of mantle cell lymphoma
Lymphadenopathy and/or lymphocytosis in older males –> can look clinically like CLL

Sites involved in mantle cell lymphoma
Lymph nodes > bone marrow, spleen, peripheral blood, GI tract
Morphology of mantle cell lymphoma
Peripheral blood smear: small lymphocytes, little cytoplasm; “smudge” cells
Lymph node: Usually homogenous effacement, ‘starry sky’

Immunophenotype of of mantle cell lymphoma
Similair to CLL
Cytogenetics of of mantle cell lymphoma
t(11;14)(IgH;CyclinD1) –> overepxression of cyclin D1 pushes the cell through the cell cycle G1 to S
Clincal presentation of Burkitt lymphoma (sporadic)
Abdominal/pelvic mass in sporadic form
–> Dysfunctional memory B cells
Sites involved in Burkitt lymphoma (sporadic)
Morphology of Burkitt lymphoma (sporadic)
Cytology: Intermediate sized cells with basophilic vacuolated cytoplasm
Tissue: Usually homogenous effacement, high growth rate, ‘starry sky’

Clinical presentation of Burkitt lymphoma (endemic)
Jaw/facial bone mass in child (age 4-7) in a p. falciparum malaria-endemic area (Ghana, Papua New Guinea)
Cytogenetics of Burkitt lymphoma
Translocation of an oncogene (MYC on 8q24) to an Ig promoter
t8;14
Morphology of Burkitt lymphoma (endemic)
Same as sporadic
Cytology: Intermediate sized cells with basophilic vacuolated cytoplasm
Tissue: Usually homogenous effacement, high growth rate, ‘starry sky’

Immunophenotype of Burkitt lymphoma (sporadic or endemic)
Typical B-cell markers (CD10, CD19, CD20)
CD22+, CD79+, Ki-67+